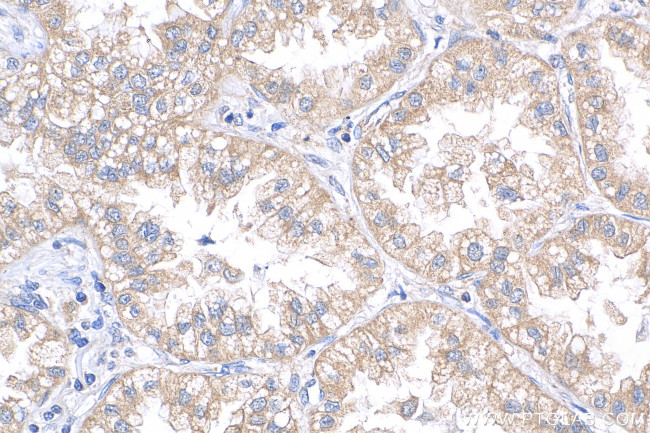
CMPK2 Antibody in Immunohistochemistry (Paraffin) (IHC (P))

Search
Proteintech
CMPK2 Polyclonal Antibody
{{$productOrderCtrl.translations['antibody.pdp.commerceCard.promotion.promotions']}}
{{$productOrderCtrl.translations['antibody.pdp.commerceCard.promotion.viewpromo']}}
{{$productOrderCtrl.translations['antibody.pdp.commerceCard.promotion.promocode']}}: {{promo.promoCode}} {{promo.promoTitle}} {{promo.promoDescription}}. {{$productOrderCtrl.translations['antibody.pdp.commerceCard.promotion.learnmore']}}
产品信息
25877-1-AP
种属反应
已发表种属
宿主/亚型
分类
类型
抗原
偶联物
形式
浓度
规格
纯化类型
保存液
内含物
保存条件
运输条件
产品详细信息
Immunogen sequence: MAFARRLLRG PLSGPLLGRR GVCAGAMAPP RRFVLELPDC TLAHFALGAD APGDADAPDP RLAALLGPPE RSYSLCVPVT PDAGCGARVR AARLHQRLLH QLRRGPFQRC QLLRLLCYCP GGQAGGAQQG FLLRDPLDDP DTRQALLELL GACQEAPRPH LGEFEADPRG QLWQRLWEVQ DGRRLQVGCA QVVPVPEPPL HPVVPDLPSS VVFPDREAAR AVLEECTSFI PEARAVLDLV DQCPKQIQKG KFQVVAIEGL DATGKTTVTQ SVADSLKAVL LKSPPSCIGQ WRKIFDDEPT IIRRAFYSLG NYIVASEIAK ESAKSPVIVD RYWHSTATYA IATEVS
靶标信息
UMP-CMP kinase 2 (CMPK2) is the first nucleoside monophosphate kinase that has been identified in human mitochondria. It is a component of the salvage pathway for nucleotide synthesis that may participate in terminal differentiation of monocytic cells. There are two distinct domains of CMPK2: the N-terminal domain with unknown function and the C-terminal domain with the kinase function, suggesting that CMPK2 may be a bifunctional protein with other biological functions in addition to its UMP-CMP kinase activity. CMPK2 may participate in dUTP and dCTP synthesis and is responsible for phosphorylation of dCMP and dUMP in mitochondria. CMPK2 is actively involved in macrophage activation and the inflammatory response.
仅用于科研。不用于诊断过程。未经明确授权不得转售。
生物信息学
蛋白别名: cytidine monophosphate (UMP-CMP) kinase 2, mitochondrial; cytidylate kinase 2; mitochondrial UMP-CMP kinase; Nucleoside-diphosphate kinase; thymidine monophosphate kinase 2; thymidylate kinase family LPS-inducible member; thymidylate kinase homologue; Thymidylate kinase LPS-inducible member; TYKi; UMP-CMP kinase 2, mitochondrial; UMP/CMP kinase; unnamed protein product
基因别名: 1200004E04Rik; CMPK2; IBGC10; NDK; TDKI; TMPK2; TYKi; UMP-CMPK2
UniProt ID: (Human) Q5EBM0, (Mouse) Q3U5Q7
Entrez Gene ID: (Human) 129607, (Rat) 314004, (Mouse) 22169